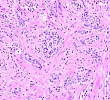
product

行为学实验
分析软件记录小鼠倒挂6 min内的活动情况。 强迫游泳(D15,Day 45):测试之前,将小鼠放入行为学房间适应1 h,实验时将小鼠放入装有高为15 ㎝的水,温度保持在23-25℃,视频录制小鼠6 min内的活动情况,并使用视频分析软件分析后4 min小鼠不动的时间。
地区:深圳服务名称:动物实验
¥600-1500

兔子桡骨血管的Micro-CT扫描
兔子桡骨血管的Micro-CT扫描 实验目的:通过Micro-CT仪器检测兔子桡骨附近的血管(该血管已注射造影剂),用以观察桡骨附近的血管的形态结构以及分布情况。 实验方法:实验通过小动物Micro-CT扫描设备完成的。将实验样品放入Micro-CT仪器内进行扫描,扫描完成后对得
¥400-800

CRO服务/猪/犬
利明生物在广州、南京等地设立实验室、生产基地和运营办事处,临床前CRO服务与实验动物销售网络遍及全国。基于猪/犬,可定制数百种模型实验,应用于产品功效与安全评价、临床前药效评价与药物筛选、生物学质量控制、行为分析、基因编辑、科研课题等技术服务,周期短、费用低、高效专业。 具备普通
¥3000-10000

ApoE KO自发动脉粥样硬化硬化小鼠模型
项目介绍: 简称:ApoE(动脉粥样硬化小鼠模型) 品系类型:基因敲除 繁殖方式:阳性(T)♂×阳性(T)♀ 应用领域: 1. 糖尿病和肥胖研究 2. 神经生物学研究 3. 心血管研究 4. 药效评价 背景介绍: 年老的ApoE基因缺陷小鼠(大于17个月)在脑部晶状胆固醇裂隙,脂
提供商:bioyxs
¥1600-2000

常规腔镜手术动物实验
常规腔镜手术动物实验 一、前言 我中心可开展血管介入科、泌尿科、呼吸科及消化科等腔镜类手术医疗器械性能评估,通过动物试验收集数据,为后续临床评价提供详细的数据支撑。 常选用犬、猪等不同种类的动物模型和相应的手术方式,体内模型各类腔镜临床使用指标是否满足要求。 二、硬件设施 基础设
地区:深圳服务名称:常规腔镜手术动物实验
¥10000-12000

转基因小鼠技术服务
技术服务详细描述 同源重组方法(及基因敲除小鼠) 如果研究者想用基因工程载体代替其等位基因,同时又不会对基因组上的其他基因造成任何影响,那么最好的选择就是进行同源重组。要进行这一操作,首先要知道靶基因的DNA序列(如图1)。有了这一信息,用你的目标序列替换任何靶基因就都成为可能。
地区:广州市萝岗区服务名称:转基因小鼠
¥500000-1000000